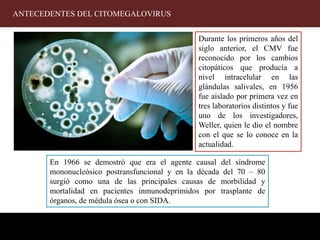

El citomegalovirus (CMV) es un virus ampliamente distribuido que afecta a personas de todas las edades y puede causar complicaciones severas en individuos inmunocomprometidos y en recién nacidos, donde el 10% de los infectados puede presentar secuelas graves. Su transmisión ocurre principalmente a través de fluidos corporales y puede provocar citomegalia en células infectadas. El diagnóstico temprano de la infección congénita es crucial, y se realiza mediante pruebas serológicas y cultivos virológicos durante las primeras semanas de vida.